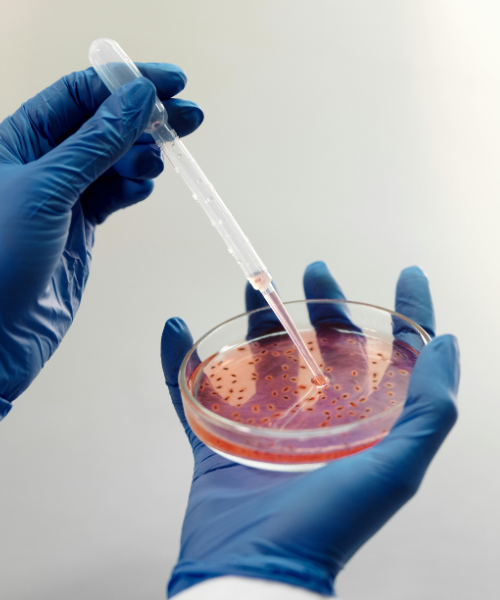

- Detection of Pathogens – Identifying harmful microorganisms such as E. coli, Salmonella, Staphylococcus aureus, Pseudomonas aeruginosa, and Listeria monocytogenes, Enterobacteriaceae, E. Coli 0157 and Vero or Shiga Toxin producing E. Coli, Vibrio Cholera etc.
- Enumeration of Spoilage Micro-Flora – Measuring microbial loads that can lead to product degradation
- Bacterial Enterotoxins – Detecting toxins produced by pathogenic bacteria in food and pharmaceuticals
- Disinfection Efficacy Testing – Evaluating the effectiveness of disinfectants used in pharmaceuticals, healthcare, and industrial settings
- Preservative Efficacy Testing (PET) – Assessing the ability of preservatives to prevent microbial contamination in cosmetics, pharmaceuticals, and personal care products
- Sterility Testing & Bio-Burden Analysis – Ensuring that sterile products, including injectable, ophthalmic solutions, and surgical instruments, are free from microbial contamination
- Microbiological Monitoring of Indoor Air – Measuring microbial load in controlled environments such as cleanrooms, hospitals, and food production units
- Antimicrobial Efficacy of Water Purification Devices & Filters – Assessing the ability of water filtration systems to eliminate microbial contaminants
